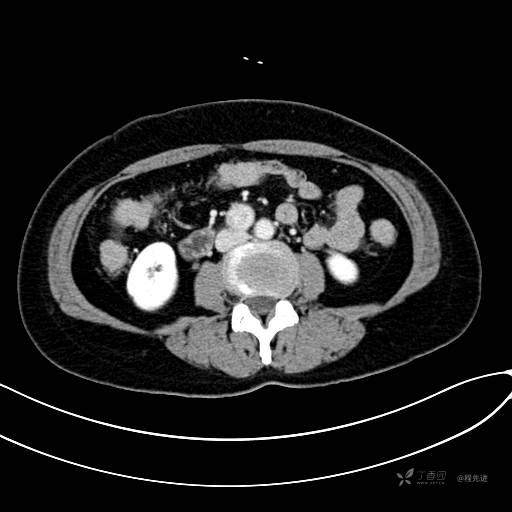
img

红五月特别精彩病例|黑便9天,晕厥1次,典型病例分享,秒吧【病理已公布】
患者性别:女
患者年龄:59岁
主诉:黑便9天,晕厥1次
简要病史:患者9天前无明显诱因下出现黑便,无鲜血便,无进食后腹部不适,于当地医院就诊查大便隐血阳性,未予特殊处理。2天后患者突发晕厥,大便失禁,呈黑色粘液样,无四肢抽搐,无口吐白沫,持续1-2分钟后清醒,急诊至***医院治疗,查胃镜提示:慢性萎缩性胃炎伴糜烂(C1),十二指肠隆部肿块伴糜烂出血,遂住院予止血、护胃治疗5天,症状逐渐好转。
发病以来,神清,精神可,胃纳睡眠安,二便无殊,体重无明显改变。
既往史:否认“高血压”、“糖尿病”“心脏病”、“冠心病”、“肾炎”。
实验室检查:肿标(-);WBC:3.6*109/L;HB: 95g/L;
CT平扫

















CT增强动脉期

















CT增强门脉期

















CT增强静脉期

CT增强冠状位重建













您的诊断是?